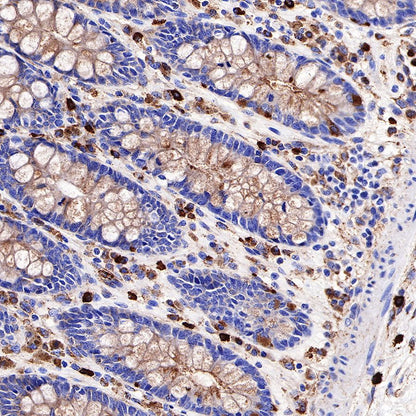
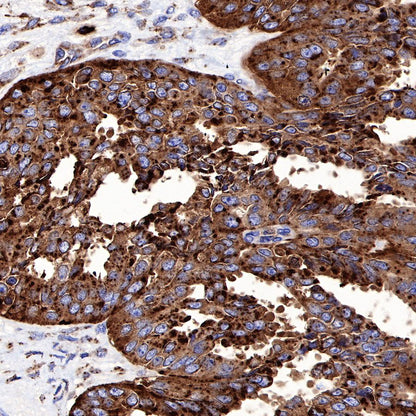

WB result of CD63 Rabbit mAb
Primary antibody: CD63 Rabbit mAb at 1/500 dilution
Lane 1: Jurkat whole cell lysate 20 µg
Lane 2: SK-MEL-28 whole cell lysate 20 µg
Lane 3: THP-1 whole cell lysate 20 µg
Lane 4: 293T whole cell lysate 20 µg
Negative control: Jurkat whole cell lysate
Secondary antibody: Goat Anti-Rabbit IgG, (H+L), HRP conjugated at 1/10000 dilution
Predicted MW: 25 kDa
Observed MW: 25~60 kDa, 25~100 kDa
Exposure time: 60s
Product Details
Product Details
Product Specification
| Host | Rabbit |
| Antigen | CD63 |
| Synonyms | Granulophysin, LAMP-3, Limp1, OMA81H, Tspan-30 |
| Immunogen | Recombinant Protein |
| Location | Secreted, Cell membrane, Melanosome |
| Accession | P08962 |
| Clone Number | SDT-230-3 |
| Antibody Type | Rabbit mAb |
| Application | WB, IHC-P |
| Reactivity | Hu |
| Purification | Protein A |
| Research Area | Exosomes |
| Concentration | 0.25 mg/ml |
| Physical Appearance | Liquid |
| Storage Buffer | PBS, 40% Glycerol, 0.05% BSA, 0.03% Proclin 300 |
| Stability & Storage | 12 months from date of receipt / reconstitution, -20 °C as supplied |
Dilution
| application | dilution | species |
| WB | 1:500 | |
| IHC-P | 1:1000-1:2000 |
Background
CD63 is a member of the tetraspanin superfamily, a cluster of cell surface associated membrane proteins with four transmembrane domains [PubMed: 31882993, PubMed: 25921073]. Tetraspanins have been shown to be involved in many cellular functions including cell motility, adhesion, differentiation,activation, immune response, and tumor cell migration and invasion. Post translational modification of CD63 results in its ability to organize and form tetraspanin-enriched microdomains (TEMs) on membranes. The formation of TEMs allows interaction with components such as integrin molecules, immunoglobulins, proteoglycans, cadherins, and signaling molecules on the cell surface [PubMed: 31882993, PubMed: 15992681]. CD63 is highly enriched in late endosomal and lysosomal compartments after being endocytosed from the cell surface through the clathrin-coated vesicles.
Picture
Picture
Western Blot

Immunohistochemistry

IHC shows positive staining in paraffin-embedded human colon. Anti-CD63 antibody was used at 1/2000 dilution, followed by a HRP Polymer for Mouse & Rabbit IgG (ready to use). Counterstained with hematoxylin. Heat mediated antigen retrieval with Tris/EDTA buffer pH9.0 was performed before commencing with IHC staining protocol.

IHC shows positive staining in paraffin-embedded human spleen. Anti-CD63 antibody was used at 1/2000 dilution, followed by a HRP Polymer for Mouse & Rabbit IgG (ready to use). Counterstained with hematoxylin. Heat mediated antigen retrieval with Tris/EDTA buffer pH9.0 was performed before commencing with IHC staining protocol.

IHC shows positive staining in paraffin-embedded human tonsil. Anti-CD63 antibody was used at 1/2000 dilution, followed by a HRP Polymer for Mouse & Rabbit IgG (ready to use). Counterstained with hematoxylin. Heat mediated antigen retrieval with Tris/EDTA buffer pH9.0 was performed before commencing with IHC staining protocol.

IHC shows positive staining in paraffin-embedded human colon cancer. Anti-CD63 antibody was used at 1/1000 dilution, followed by a HRP Polymer for Mouse & Rabbit IgG (ready to use). Counterstained with hematoxylin. Heat mediated antigen retrieval with Tris/EDTA buffer pH9.0 was performed before commencing with IHC staining protocol.

IHC shows positive staining in paraffin-embedded human lung adenocarcinoma. Anti-CD63 antibody was used at 1/1000 dilution, followed by a HRP Polymer for Mouse & Rabbit IgG (ready to use). Counterstained with hematoxylin. Heat mediated antigen retrieval with Tris/EDTA buffer pH9.0 was performed before commencing with IHC staining protocol.

IHC shows positive staining in paraffin-embedded human ovarian carcinoma. Anti-CD63 antibody was used at 1/1000 dilution, followed by a HRP Polymer for Mouse & Rabbit IgG (ready to use). Counterstained with hematoxylin. Heat mediated antigen retrieval with Tris/EDTA buffer pH9.0 was performed before commencing with IHC staining protocol.

IHC shows positive staining in paraffin-embedded human melanoma. Anti-CD63 antibody was used at 1/1000 dilution, followed by a HRP Polymer for Mouse & Rabbit IgG (ready to use). Counterstained with hematoxylin. Heat mediated antigen retrieval with Tris/EDTA buffer pH9.0 was performed before commencing with IHC staining protocol.